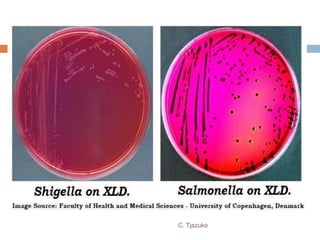
C. Tjazuko
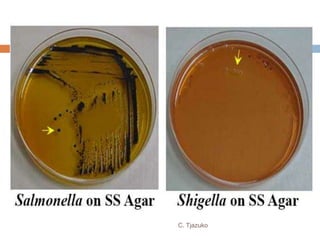
C. Tjazuko

The document is a detailed overview of Shigella and Salmonella, highlighting their morphology, classification, pathogenesis, clinical manifestations, and laboratory diagnosis. It discusses Shigella as an agent of bacillary dysentery and Salmonella's role in enteric fevers, including typhoid and non-typhoidal infections. Treatment options and diagnosis methods, including culture and serological testing, are also covered.